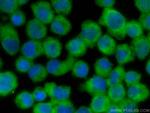
DGKA Antibody in Immunocytochemistry (ICC/IF)

Search
Proteintech
DGKA Polyclonal Antibody, CoraLite® Plus 488
{{$productOrderCtrl.translations['antibody.pdp.commerceCard.promotion.promotions']}}
{{$productOrderCtrl.translations['antibody.pdp.commerceCard.promotion.viewpromo']}}
{{$productOrderCtrl.translations['antibody.pdp.commerceCard.promotion.promocode']}}: {{promo.promoCode}} {{promo.promoTitle}} {{promo.promoDescription}}. {{$productOrderCtrl.translations['antibody.pdp.commerceCard.promotion.learnmore']}}
产品信息
CL488-11547
种属反应
宿主/亚型
分类
类型
抗原
偶联物
激发/发射光谱
形式
浓度
规格
纯化类型
保存液
内含物
保存条件
运输条件
产品详细信息
Immunogen sequence: LEFTFKLYD TDRNGILDSS EVDKIILQMM RVAEYLDWDV SELRPILQEM MKEIDYDGSG SVSQAEWVRA GATTVPLLVL LGLEMTLKDD GQHMWRPKRF PRPVYCNLCE SSIGLGKQGL SCNLCKYTVH DQCAMKALPC EVSTYAKSRK DIGVQSHVWV RGGCESGRCD RCQKKIRIYH SLTGLHCVWC HLEIHDDCLQ AVGHECDCGL LRDHILPPSS IYPSVLASGP DRKNSKTSQK TMDDLNLSTS EALRIDPVPN THPLLVFVNP KSGGKQGQRV LWKFQYILNP RQVFNLLKDG PEIGLRLFKD VPDSRILVCG GDGTVGWILE TIDKANLPVL PPVAVLPLGT GNDLARCLRW GGGYEGQNLA KILKDLEMSK VVHMDRWS
靶标信息
The protein encoded by this gene belongs to the eukaryotic diacylglycerol kinase family. It acts as a modulator that competes with protein kinase C for the second messenger diacylglycerol in intracellular signaling pathways. It also plays an important role in the resynthesis of phosphatidylinositols and phosphorylating diacylglycerol to phosphatidic acid. Alternative splicing occurs at this locus and four transcript variants encoding the same protein have been identified.
仅用于科研。不用于诊断过程。未经明确授权不得转售。
篇参考文献 (0)
生物信息学
蛋白别名: 80 kDa diacylglycerol kinase; DAG kinase alpha; DGK-alpha; Diacylglycerol kinase alpha; diacylglycerol kinase alpha Flt2-Pr2; diacylglycerol kinase, alpha 80kDa; Diglyceride kinase; Diglyceride kinase alpha; MGC12821; MGC42356; truncated diacylglycerol kinase alpha Flt1-Pr1; truncated diacylglycerol kinase alpha Flt1-Pr2; unnamed protein product
基因别名: 80kDa; AW146112; DAGK; DAGK1; DGK-alpha; DGKA
UniProt ID: (Human) P23743, (Mouse) O88673, (Rat) P51556
Entrez Gene ID: (Human) 1606, (Mouse) 13139, (Rat) 140866